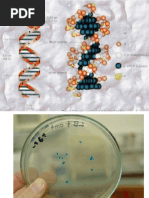

0% encontró este documento útil (0 votos)
354 vistas71 páginasGenetica Microbiana
Este documento trata sobre la genética microbiana. Explica conceptos como el tamaño y organización de los genomas procariotas y eucariotas, la replicación, transcripción y traducción del ADN, y características de los elementos genéticos como los plásmidos y su papel en la transferencia de resistencias antibióticas.
Cargado por
KNayDerechos de autor
© © All Rights Reserved
Nos tomamos en serio los derechos de los contenidos. Si sospechas que se trata de tu contenido, reclámalo aquí.
Formatos disponibles
Descarga como PDF, TXT o lee en línea desde Scribd
0% encontró este documento útil (0 votos)
354 vistas71 páginasGenetica Microbiana
Este documento trata sobre la genética microbiana. Explica conceptos como el tamaño y organización de los genomas procariotas y eucariotas, la replicación, transcripción y traducción del ADN, y características de los elementos genéticos como los plásmidos y su papel en la transferencia de resistencias antibióticas.
Cargado por
KNayDerechos de autor
© © All Rights Reserved
Nos tomamos en serio los derechos de los contenidos. Si sospechas que se trata de tu contenido, reclámalo aquí.
Formatos disponibles
Descarga como PDF, TXT o lee en línea desde Scribd